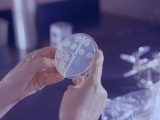
Photo #46333

TB Risk Should not Depend on Where We Are Born
21 March 2026, 08:15
21 March 2026, 08:15 
WASHINGTON DC, March 20 (IPS) - In many high-income countries, even a small number of tuberculosis (TB) diagnoses can generate headlines and prompt a rapid public health response. Recent situations in U.S. cities such as Seattle and San Francisco illustrate this, where media coverage has focused on the number of children being tested after TB disease was identified in a school.
Read the full story, “TB Risk Should not Depend on Where We Are Born”, on globalissues.org →
Source:
Global Issues News Headlines
Comments (0)
Do you like the page?
Would you like to share the page with your friends?